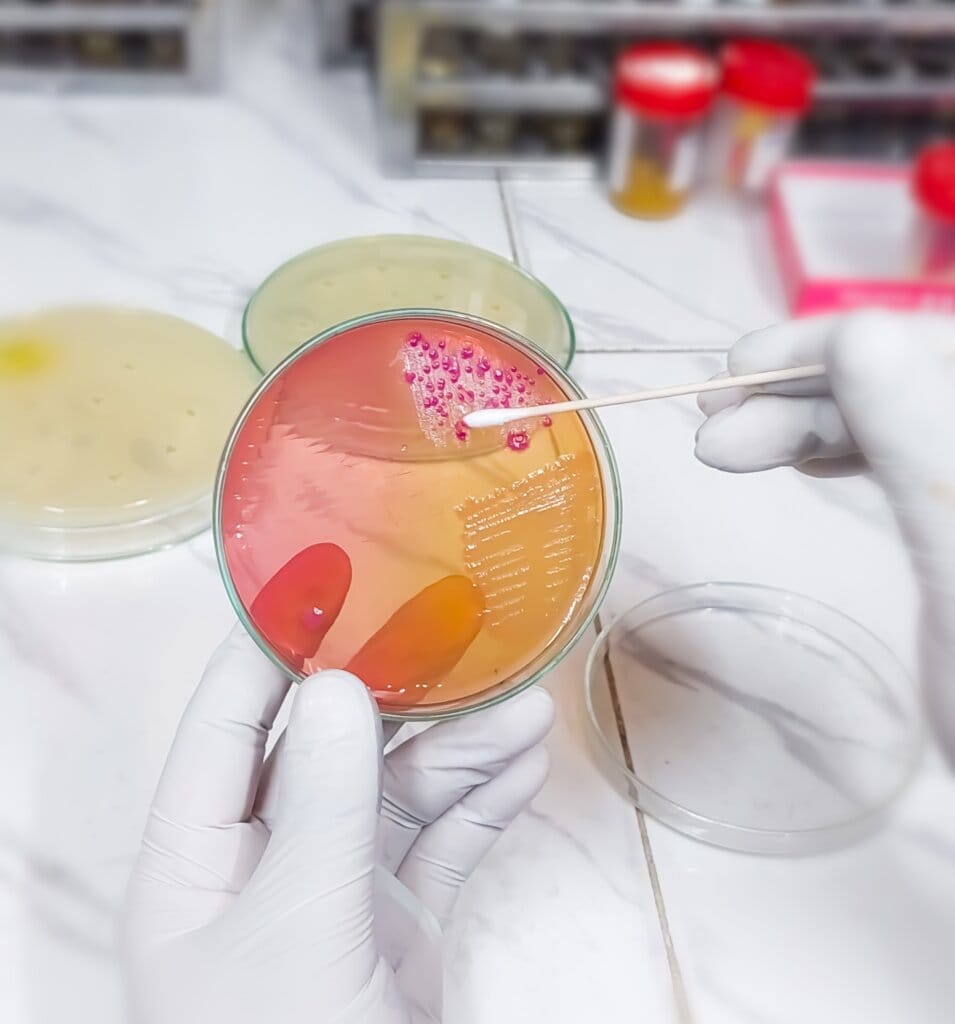
Taking Samples from petri dish

Efficacy Testing for Household Insecticides and Repellents
Household insecticides and repellents hold a significant place in controlling pests against both public health and comfort. Ants, cockroaches, bed bugs and dangerous pests like mosquitoes that carry deadly diseases call for the effectiveness of controlling their population to ensure safe and sanitary living conditions. This very reason makes household insecticide efficacy testing a step […]
Efficacy Testing for Household Insecticides and Repellents Read More »